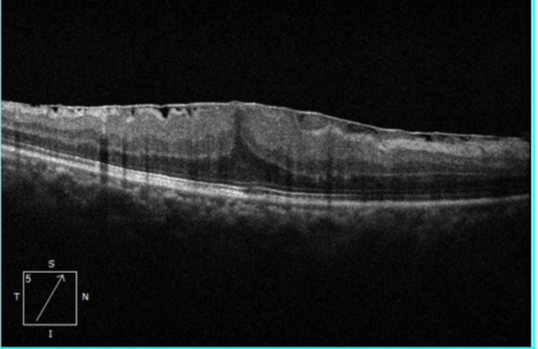
黄斑前膜该怎么治疗?武汉普瑞眼科许泽骏科普症状和手术治疗方式

在门诊日常接诊工作中会经常遇见得了「黄斑前膜」的病人,当告知患者病情时大部分病人会很迷茫,原因在于对此种疾病没有什么太多了解,也不知道这个病严不严重?,会不会瞎眼睛?,该怎么治疗?,一听说要做手术就变很焦虑。为了让大家了解这个疾病缓解焦虑,武汉普瑞眼科医院眼底病科许泽骏副院长和大家一起聊一聊这个疾病。
想象一下,我们眼睛最核心的视觉区域——黄斑,就像手机最精密的摄像头传感器。正常情况下,它表面非常干净光滑,能呈现清晰、高分辨率的图像。

黄斑前膜,通俗讲,就是在这块「传感器」表面,自发地长出了一层 非正常的、半透明的「细胞薄膜」。这层膜就像一张皱巴巴的、质量很差的「手机贴膜」,贴在珍贵的传感器上。这层膜会收缩、皱缩。导致下面的「传感器」(黄斑)被拉扯、变形,甚至水肿。最终导致我们看到的图像 扭曲、变形、模糊。
二、分类:
特发性:指大部分情况(约 80%)下找不到明确的原因,与年龄增长、玻璃体后脱离有关,常见于 50 岁以上人群。
继发性:少数情况由其他眼病引起,如视网膜静脉阻塞、糖尿病视网膜病变、葡萄膜炎、眼内手术或外伤等。
三、为什么会得这个病?(病因与风险因素)
1. 年龄增长(最主要因素):随年龄增长,眼球内的凝胶状物质(玻璃体)会液化、收缩,与视网膜分离(即「玻璃体后脱离」)。这个分离过程可能刺激视网膜表面,启动修复机制,一些细胞(主要是胶质细胞)在黄斑区迁移、增殖,最终形成膜。
2. 眼部疾病或手术史:如上文提到的视网膜血管性疾病、炎症、眼外伤、视网膜激光光凝或眼内手术(如白内障手术、视网膜脱离手术)后。
3. 与性别关系不大,男女发病率相近

四、有哪些症状?
症状的严重程度与膜的厚度、收缩力密切相关。早期可能 毫无症状。
典型症状包括:
1. 视物变形:看直线变弯、扭曲(如门框、窗户线变弯),这是最特征性的症状。
2. 视力下降:缓慢的、进行性的视力模糊,通常不会完全失明。
3. 视物显小或显大:因黄斑被拉扯变形,导致看到的物体比实际更小或更大。
4. 单眼复视:用一只眼看东西时出现重影。
5. 中央暗点或视觉灰区:视野中心有固定的阴影或灰蒙蒙的感觉。
⚠️ 重要提示:如果你发现 看东西变形,无论视力是否下降,都应立即就医!
五、如何诊断?
诊断主要依靠眼科特殊检查,普通视力检查和眼底镜检查可能发现不了早期或轻微的病变。
1. OCT(光学相干断层扫描):这是诊断和评估黄斑前膜的「金标准」。它可以无创、高分辨率地「断层扫描」黄斑,清晰显示前膜的存在、厚度、以及其是否导致黄斑水肿、结构层次是否紊乱。OCT 也是监测病情变化和决定手术时机的关键工具。
2. 眼底血管造影:当怀疑伴有黄斑水肿或血管性疾病时使用。
3.Amster 方格表:患者在家自查的工具,用于监测视物变形是否加重。如果看到方格扭曲、缺失,提示病情可能进展。
术前黄斑 OCT 及欧堡:

术后 黄斑 OCT 及欧堡:


如何治疗黄斑前膜?
治疗原则:并非所有黄斑前膜都需要手术!
观察随访(主要策略):
适用于:无症状或症状轻微、视力尚可、OCT 显示膜很薄且对黄牵拉不重的患者。
做法:每 6-12 个月定期复查 OCT 和视力,监测变化。很多患者的病情可以稳定多年。
手术治疗:
当出现 视力明显下降(如矫正视力低于 0.3-0.5)、视物变形严重影响生活,或 OCT 显示黄斑水肿、结构损伤加重 时考虑手术。通过 玻璃体切割术 + 黄斑前膜剥离术,切除玻璃体,然后用精细的器械小心翼翼地撕除这层「膜」,解除它对黄斑的牵拉。稳定或改善视物变形(超过 90% 的患者变形症状可改善或消失)。大部分患者术后视力有不同程度提高,但恢复程度因人而异,取决于黄斑被牵拉的时间和严重程度。通常需要数月缓慢恢复。
风险:如所有内眼手术一样,存在感染、出血、视网膜脱离、白内障加速(几乎 100% 会发生或加重)等风险,但发生率在经验丰富的医生手中很低。
药物治疗:目前 没有 特效眼药水可以消除或预防黄斑前膜。如果伴有黄斑水肿,医生可能会考虑使用抗炎药物。

预后与总结
1. 不会导致完全失明:黄斑前膜是良性疾病,病程进展缓慢,主要影响中心视力,周边视力不受影响。
2. 手术成功率很高:对于达到手术指征的患者,手术是唯一有效的治疗方法,成功率高,能显著改善生活质量。
3. 关键在于定期监测:早期发现、定期监测、把握正确的手术时机是获得良好预后的关键。
4. 与白内障关系:手术后会加速白内障发展,但可以在术后合适时机通过白内障手术一并解决。

好文章,需要你的鼓励
















